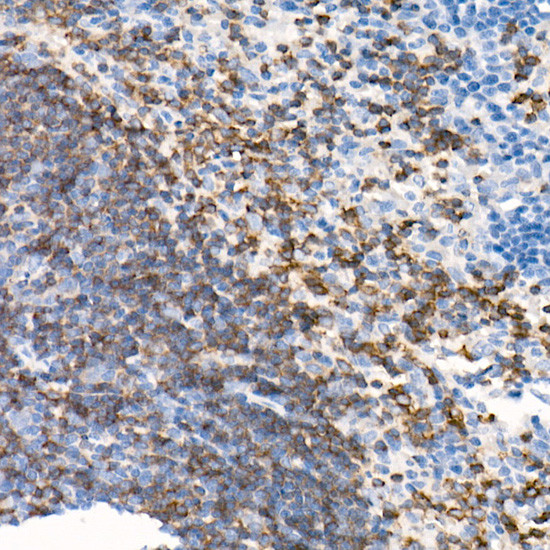
CD79b Antibody in Immunohistochemistry (Paraffin) (IHC (P))

Search
Invitrogen
CD79b Recombinant Rabbit Monoclonal Antibody (9A7V6)
{{$productOrderCtrl.translations['antibody.pdp.commerceCard.promotion.promotions']}}
{{$productOrderCtrl.translations['antibody.pdp.commerceCard.promotion.viewpromo']}}
{{$productOrderCtrl.translations['antibody.pdp.commerceCard.promotion.promocode']}}: {{promo.promoCode}} {{promo.promoTitle}} {{promo.promoDescription}}. {{$productOrderCtrl.translations['antibody.pdp.commerceCard.promotion.learnmore']}}
图: 1 / 6
CD79b Antibody (MA5-42849) in IHC (P)






产品信息
MA5-42849
种属反应
宿主/亚型
Expression System
分类
类型
克隆号
抗原
偶联物
形式
浓度
纯化类型
保存液
内含物
保存条件
运输条件
RRID
产品详细信息
Positive test controls include: Raji.
靶标信息
CD79b is the B cell antigen receptor Ig beta chain (BCR-Ig beta), which associates with B cell antigen receptor Ig alpha chain to form a functional heterodimer that interacts with membrane immunoglobulin (mIg). The mIgM component binds antigen and the Ig alpha /I g beta heterodimer tranduces signals.
仅用于科研。不用于诊断过程。未经明确授权不得转售。
篇参考文献 (0)
生物信息学
蛋白别名: B-cell antigen receptor complex-associated protein beta chain; B-cell-specific glycoprotein B29; CD79; CD79b; CD79B antigen; Ig beta; Ig-beta; Immunoglobulin-associated B29 protein; immunoglobulin-associated beta; RP23-418O11.7
基因别名: AGM6; B29; CD79B; Ig-beta; IGB; Igbeta
UniProt ID: (Human) P40259, (Mouse) P15530
Entrez Gene ID: (Human) 974, (Rat) 171055, (Mouse) 15985